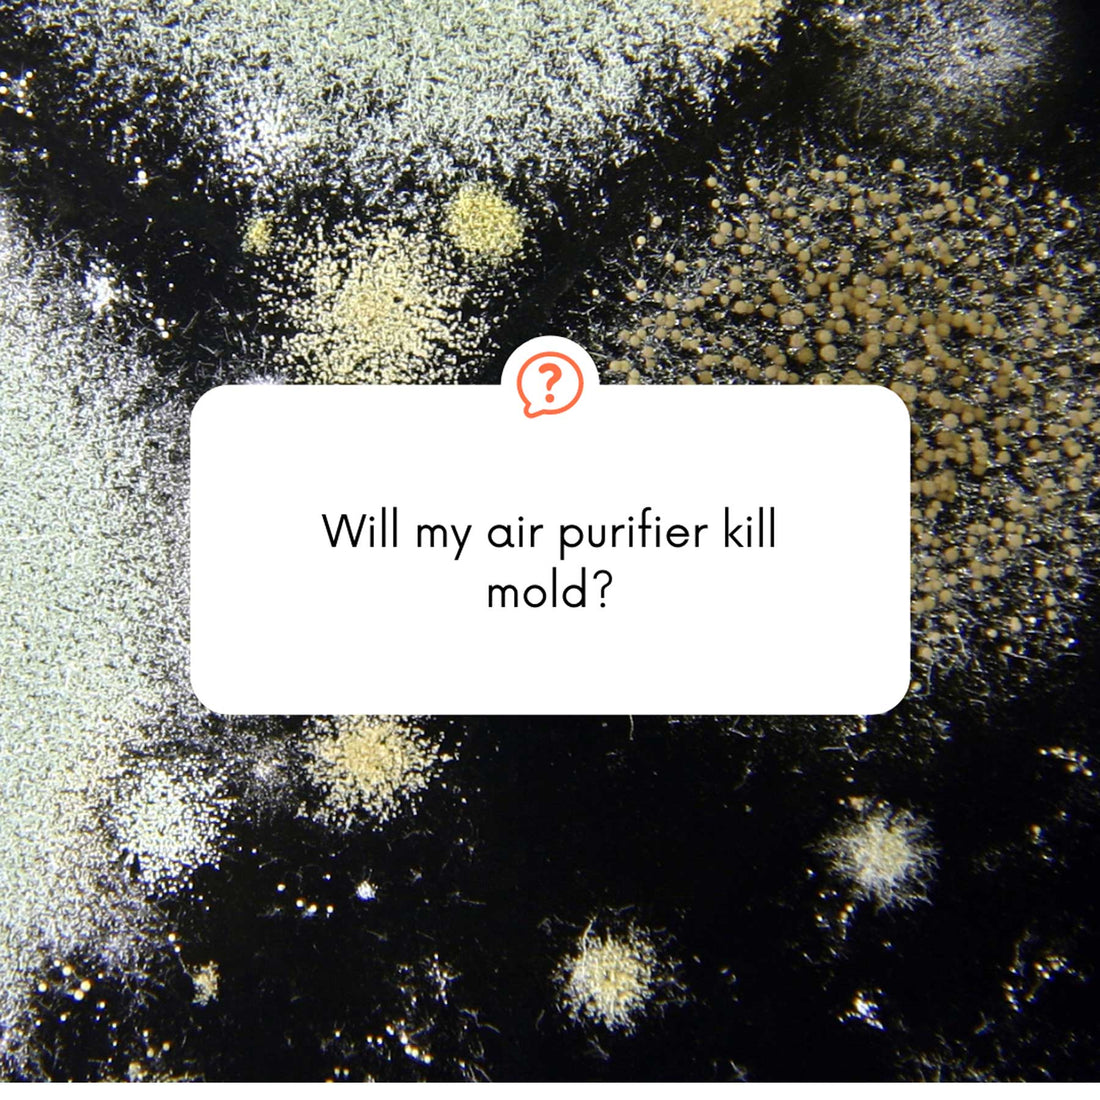
What Kind of Air Purifier Kills Mold?

When it comes to your home one of the top priorities is making sure the air inside of it is clean and safe to breathe. So naturally, you have decided to invest in an air purifier. This is a smart move, however, it’s a bit more complicated than just buying any air purifier and sticking it in your home.
Not all air purifiers will provide the results you need. In addition to how efficient an air purifier can be or the area it can cover, it is important to find one that kills the most pathogens. Here we will be discussing the types of air purifier that can kill mold.

HEPA Air Purifier
Let’s start with air purifiers that use HEPA filters. HEPA filters trap harmful particles removing them from the air, this includes mold spores. However, HEPA filters have a major draw back. They require the air you are breathing to have past through that filter.
This can be a problem because most of the air in your home never actually makes it to the filter. With so much of that air never making it there, you are ultimately left still breathing in those harmful particles.
Ozone Air Purifier
Ozone air purifying technology works by producing O3 molecules and sending them out into the air and destroying dangerous pollutants. This list of the pollutants includes mold spores.
This technology has a leg up on traditional HEPA style air purifiers; it DOES NOT require that the air be brought to the unit. The O3 molecules it sends out permeate throughout the room it is placed in. This means it can destroy much more of the air pollutants that other, filter using, purifiers would never have the chance to capture.
Photo Catalytic Oxidation Air Purifier
Photo Catalytic Oxidation (PCO) is a process that uses ultraviolet light (UV) and titanium dioxide to create hydroxyl radicals and super-oxide ions that convert harmful pathogens like bacteria and viruses into harmless carbon dioxide and can kill mold spores. While these types of purifiers can be highly effective, like the HEPA style air purifiers it requires the air to pass through the unit.
While all of these air-purifying options have the ability to kill mold spores, it is important to look at how each function and determine the best suited option to keep your home pathogen free.